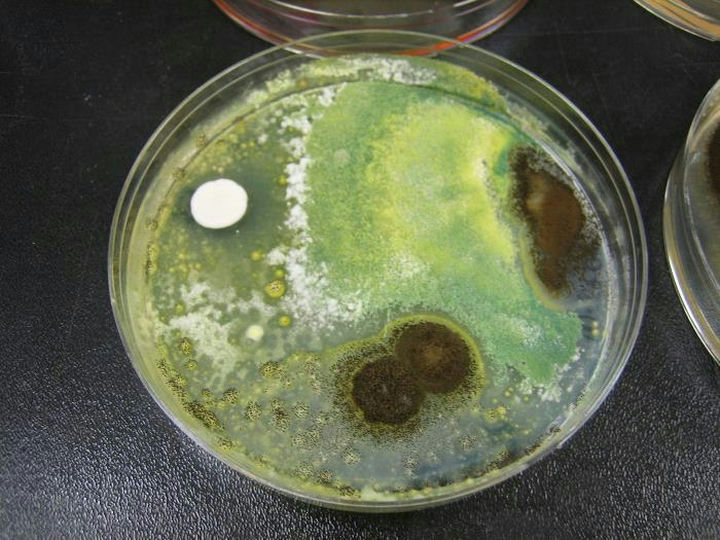
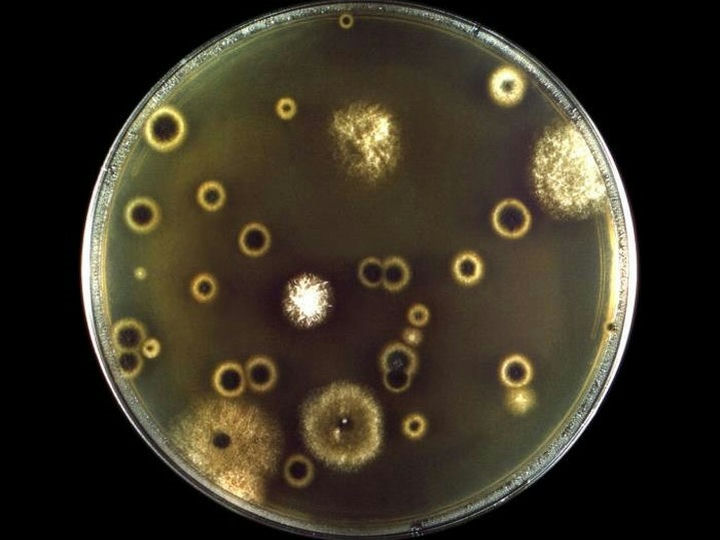

微信扫描二维码,点击右上角 ··· 按钮
转发给朋友或分享到朋友圈
【科普】显微镜带您认识不同种类的真菌
发布时间:2025-11-04
访问量:330
真菌是广泛存在于自然界的一类真核细胞生物,具有真正的细胞核和细胞器,不含叶绿素,以寄生和腐生方式吸取营养,能进行有性和无性繁殖。全世界已记载的真菌有10万种以上,只有少数真菌与人类疾病有关。观察真菌需要用到生物显微镜或者荧光显微镜,下面我们用荧光显微镜带大家看几组真菌图片,看看您认识多少?
一、白念珠菌

培养皿中的白念珠菌

白念珠菌呈圆形或者卵圆形

在荧光显微镜下,观察白念珠菌常单个出芽,有假菌丝者末端缩窄附于菌上,似“香肠”样连接,菌丝多有分隔。
二、黄曲霉

培养皿中看到,菌落生长较快,结构疏松,表面灰绿色,背面无色或略呈褐色。

在显微镜明场观察下,呈粗毛毯状或放射状皱纹,分生孢子头疏松放射状,黄色、黄绿色和棕绿色

在荧光显微镜下,可见“双异型的45度分支”,菌丝较大,菌体有许多复杂的分枝菌丝构成,紫外激发下有蓝色和绿色荧光。
三、烟曲霉

在培养皿中观察,呈绒状或絮状边缘,暗烟绿色

在生物显微镜下,烟曲霉呈现平滑薄壁的菌丝,顶囊瓶状,分生孢子梗短

在荧光显微镜下,烟曲霉的顶囊清晰,荧光成像信噪比高、对比度强
四、黑曲霉
在培养皿中菌落厚绒状、白色、黄色,局部黑色

在生物显微镜下,分生孢子为球形,菌丝发达,有隔膜和多分枝,顶部形成球形顶囊
五、新生隐球菌
在培养皿中观察,菌落初呈白色,1周后转淡黄或棕黄、湿润粘稠,状似胶汁,因为菌落新旧颜色差异会形成深色主体+浅色外环。

在生物显微镜明场观察,呈球形或橄榄球形,菌体直径4-20um,荚膜宽3-5um,不易染色。

在荧光显微镜下,烟曲霉的荧光成像信噪比高,有清晰晕圈;晕圈内可见菌体。
免责声明
本站无法鉴别所上传图片、字体或文字内容的版权,如无意中侵犯了哪个权利人的知识产权,请来信或来电告之,本站将立即予以删除,谢谢。
微信扫描二维码,点击右上角 ··· 按钮
转发给朋友或分享到朋友圈